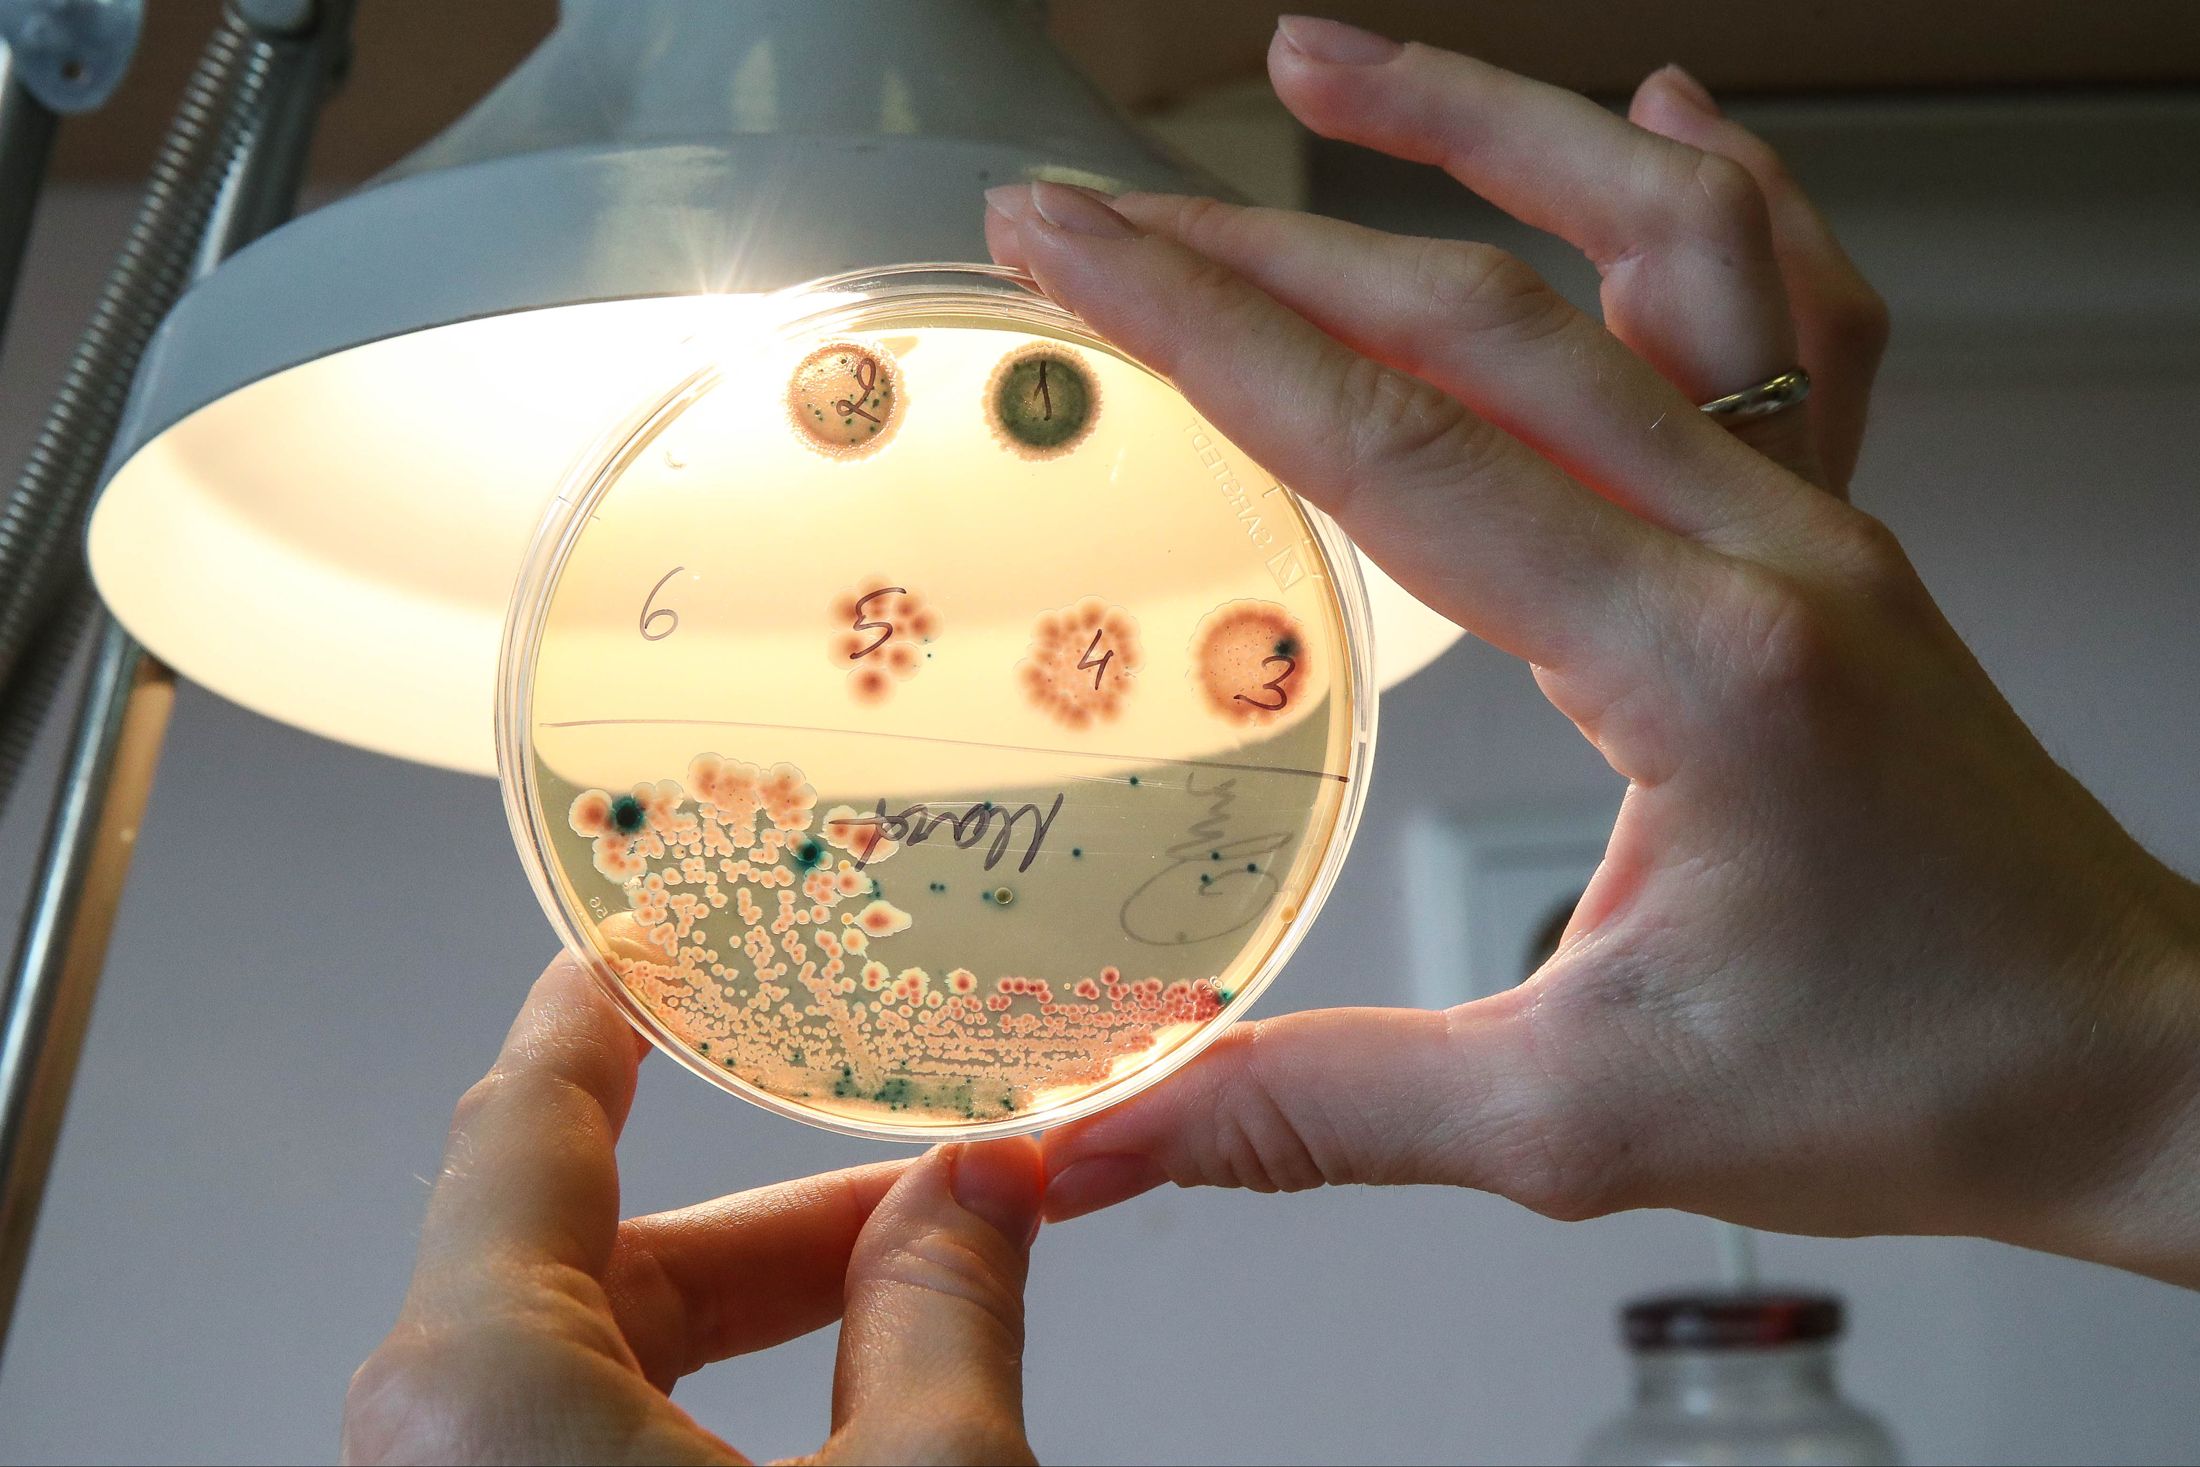

Диетолог назвала продукты, помогающие вылечиться от COVID-19
Диетолог Лера Лавски назвала продукты, помогающие вылечиться от коронавируса. По ее словам, это должна быть богатая цинком еда, сообщает РИА "Новости".
К таким продуктам относятся мясо, печень, рыба, морепродукты, зародыши пшеницы, бурый рис, овес, морковь, горох, шпинат, лук и большинство орехов.
По словам Лавски, цинк помогает формировать Т-клеточный иммунитет и включен в протоколы по лечению коронавируса. А его нехватка приводит к различным неприятным последствиям.
"При недостатке цинка почти всегда наблюдаются какие-то высыпания на коже, шелушения или воспаления, язвочки, дерматиты. Псориаз, долгое заживление ран - все это тоже может симптомами дефицита микроэлемента", - заключила врач.
Ранее диетолог Маргарита Королева назвала жиры, способные противостоять коронавирусу.